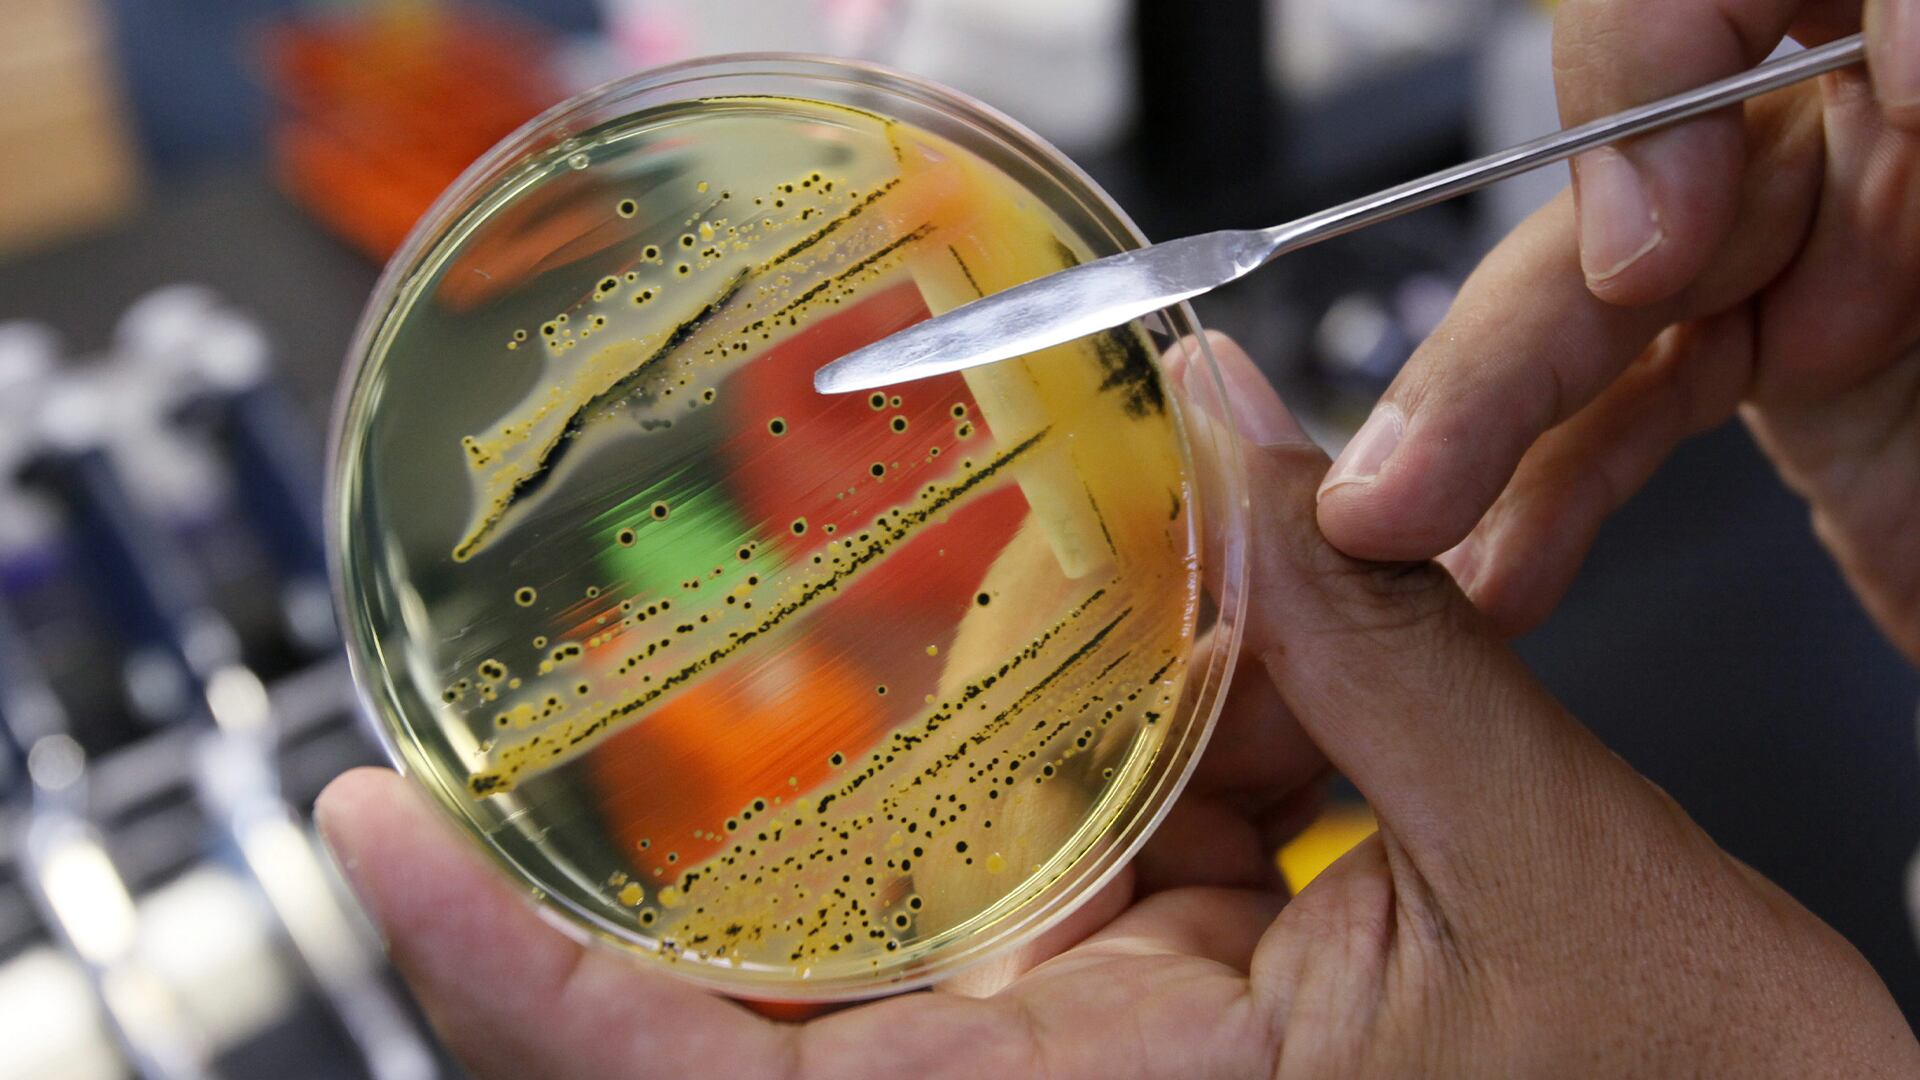

L'Agence de la santé publique du Canada (ASPC) dit mener une enquête sur une éclosion de salmonellose ultrarésistante dans six provinces, dont le Québec et le Nouveau-Brunswick.
Les partenaires provinciaux de la santé publique, l'Agence canadienne d'inspection des aliments et Santé Canada participent à cette enquête.
Selon l'ASPC, un grand nombre de personnes malades sont des enfants de 5 ans ou moins. Elle ajoute que les «infections associées à la souche responsable de cette éclosion peuvent être difficiles à traiter au moyen d'antibiotiques généralement recommandés».
Jusqu'à maintenant, deux sources ont été établies. La première est une exposition à des aliments crus préparés pour des animaux de compagnie. La seconde est un contact avec des bovins, en particulier des veaux.
Comme l'enquête suit son cours, d'autres sources pourraient être découvertes, prévient l'ASPC dans son communiqué publié samedi après-midi.
En date du 11 novembre, l'ASPC signale 40 cas confirmés d'infection à la salmonellose ultrarésistante répartis dans six provinces. Le Québec qui compte 21 cas est la province la plus touchée, suivi par l'Ontario (14) et la Nouvelle-Écosse (2). Le Manitoba, le Nouveau-Brunswick et l'Île-du-Prince-Édouard ont recensé chacun un cas.
Les personnes infectées sont tombées malades entre juillet 2020 et septembre 2023. Treize personnes ont été hospitalisées. Aucun décès n'a été signalé. Un peu moins de la moitié (43 %) des cas sont des enfants de 5 ans ou moins.
L'ASPC profite de l'occasion pour rappeler que «des salmonelles peuvent être présentes dans les aliments crus pour animaux de compagnie et dans de nombreuses espèces d'animaux, dont les chiens et les bovins». Elle recommande de toujours employer «des pratiques de manipulation salubre des aliments» lorsque que l'on prépare, cuisine ou conserve des aliments crus pour animaux de compagnie.
Elle dit ne pas recommander «de nourrir les animaux de compagnie au moyen d'aliments crus pour animaux de compagnie, en particulier dans les ménages comptant de jeunes enfants ou des personnes ayant un système immunitaire affaibli, en raison du risque accru de maladie grave».
Et si on se rend une ferme ou dans un zoo pour enfants, l'ASPC conseille de se laver les mains dès que l'on quitte des endroits réservés aux animaux, même si on n'a pas eu de contact direct avec des animaux.